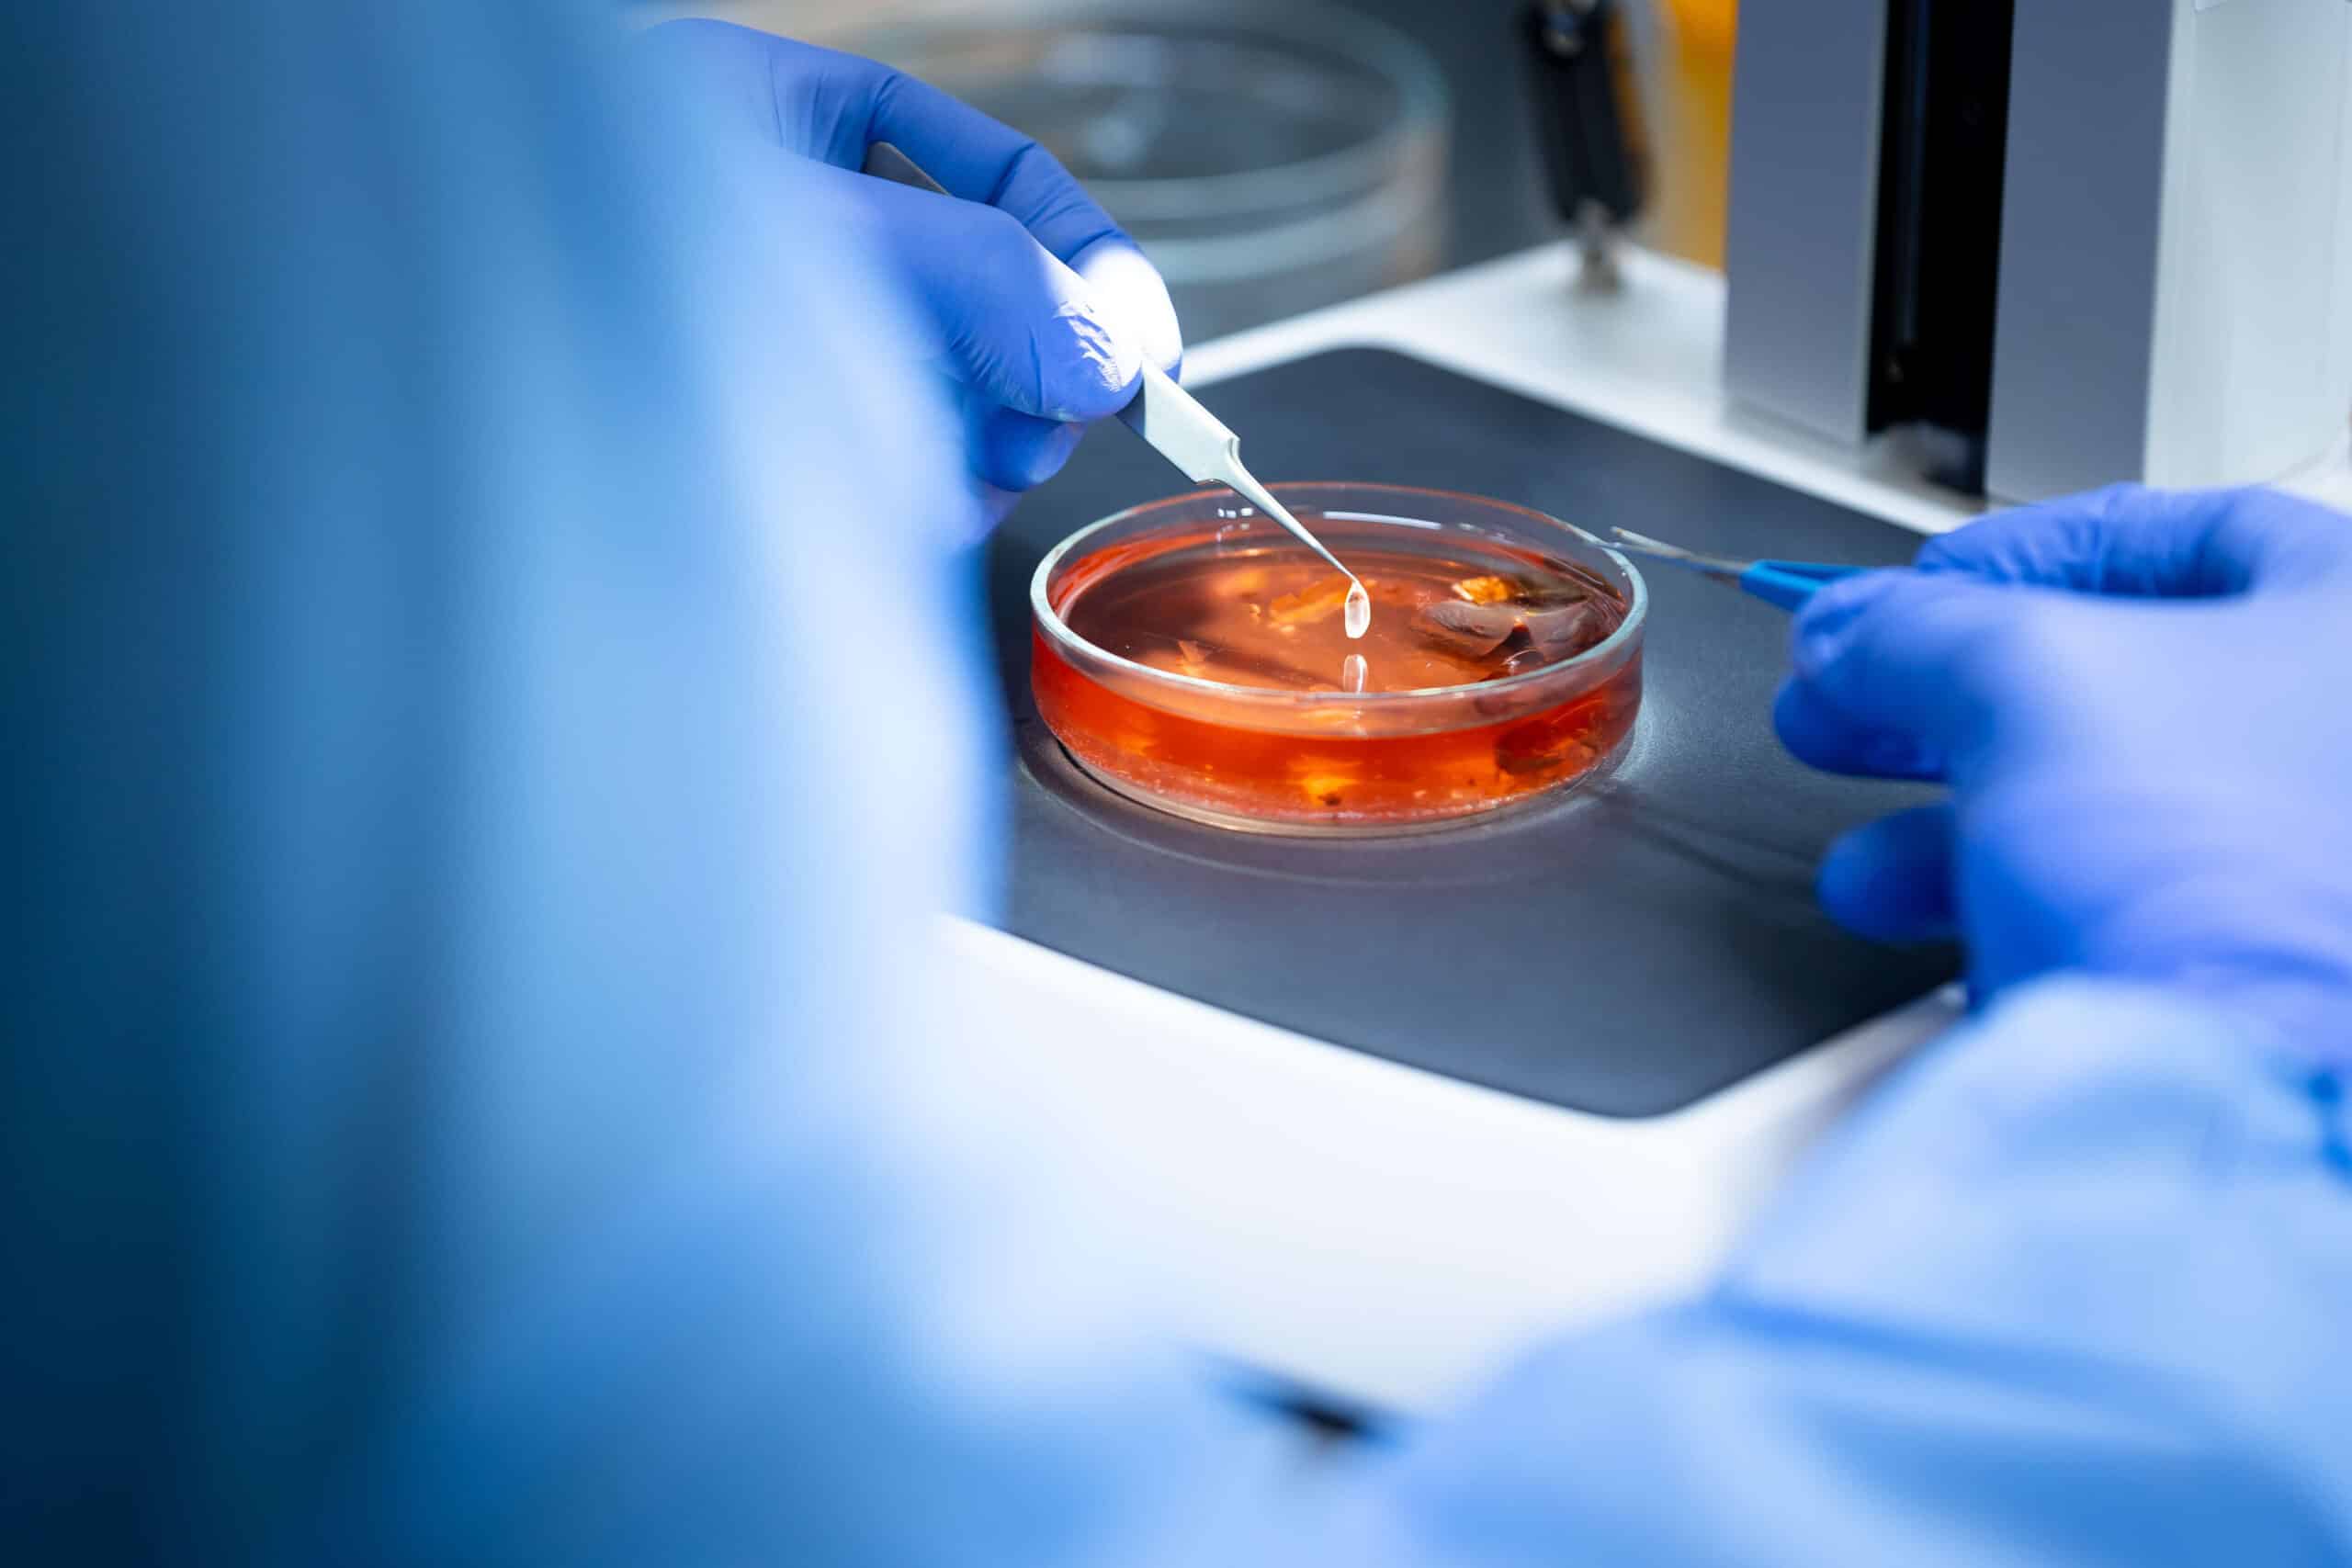

In the rankings, Semmelweis University maintains its position among the best higher education institutions, being already in the top 100 in two areas
According to the Times Higher Education (THE) World University Rankings (WUR) 2026, Semmelweis University firmly maintains its position and remains in the top 300. By increasing its total score – based on the university’s calculation – it now ranks 272nd, achieving the best result among universities in Hungary as well as Central and Eastern Europe. Semmelweis is also among the best in Medicine and Health, holding its previous position in the top 250 according to Times Higher Education’s 2025 World University Rankings by subject. The institution moved up 26 places from the year before to the 206th position, which makes it the leader not only among Hungarian universities but also in the Central and Eastern European region. Remarkably, Semmelweis University climbed 79 places in Clinical Medicine in the U.S. News Best Global Universities Rankings 2025-2026 to reach 181st position. As in previous years, the best result was achieved in the subject Cardiac and Cardiovascular Systems, where the university was listed as the 35th best in the world. According to ShanghaiRanking’s Global Ranking of Academic Subjects 2025, Semmelweis University has made progress in several disciplines. It is now among the world’s top 75 in Pharmacy & Pharmaceutical Sciences; it is among the top 400 in Public Health; it also retains its place among the top 200 in Clinical Medicine and among the top 300 in Dentistry & Oral Sciences, Medical Technology, as well as Biological Sciences.
University of the Year 2025: Semmelweis ranked first in two categories
In recognition of the achievements of Hungarian higher education, the University of the Year awards were presented for the first time last year in eight categories. The jury awarded two of these – for family-friendly operation and for building international relations – to Semmelweis University. The awards were accepted by Rector Dr. Béla Merkely, Vice-Rector for Strategy and Development Dr. Éva Szabó Feketéné, Vice-Rector for General Affairs Dr. Ferenc Bánhidy, as well as Csenge Gecsey, then President of the Students’ Union (HÖK), at a gala evening held in Budapest.
About twenty departments of the university took part in the space mission
Since its inception in 2022, Semmelweis University has been an active participant in the HUNOR (Hungarian to Orbit) Hungarian Astronaut Programme, providing medical and healthcare support. As with the selection and training of Hungarian astronauts, the university played a key role in rehabilitation, with approximately twenty departments involved in providing multidisciplinary medical and health care support for the space program. Rector Dr. Béla Merkely emphasized that the university had demonstrated exemplary interdisciplinary cooperation, even by international standards, which had contributed to the success of the HUNOR program. Hungarian research astronaut Tibor Kapu took 25 scientific experiments on board the International Space Station for his two-week mission, two of which were initiated by researchers from Semmelweis University. The scientific agenda also included a telemedicine experiment to tackle health issues – cardiovascular and vestibular – during spaceflight, as well as the use of a nanofiber-based ophthalmic drug formulation in microgravity conditions.
Four faculties and the Frigyes Korányi College for Advanced Studies celebrated anniversaries
In September, the 70-year-old Faculty of Dentistry (FOK) held an accredited scientific meeting in the Nagyvárad Square Theoretical Block (NET), where experts in the field from outside Hungary gave presentations in the international section, and on the second day, the faculty leadership summarized the history of FOK. The 50th anniversary of the Faculty of Health Sciences (ETK) was commemorated with an all-day program in the new block on Szentkirályi Street. The celebration ended with a gala evening at the Uránia National Film Theatre. The Faculty of Pharmaceutical Sciences (GYTK), also celebrating its 70th anniversary, commemorated the most important milestones as well as the influential lecturers and researchers of the past seven decades. The festive program included presentations on the effects of the reformed curriculum, new scientific and industrial collaborations, research directions, and future development plans. Several events were also organized in 2025 to mark the 75th anniversary of the founding of the Pető Institute, the predecessor of the András Pető Faculty (PAK), including a charity gala evening at the Pesti Vigadó and the András Pető Scientific and Professional Symposium.
In addition to the four faculties, the Frigyes Korányi College for Advanced Studies also celebrated its 40th anniversary with a series of jubilee events.
Conductive Education became a Hungarikum
The Collection of Hungarikums (uniquely Hungarian values worthy of distinction) has been expanded with the addition of Conductive Education based on the Pető Method. As stated at the award ceremony, the system of Conductive Education as part of Hungary’s intellectual heritage provides support to families worldwide.
Semmelweis and Westpfalz-Klinikum in Germany launch joint training as part of cross-border cooperation
As part of the cooperation between Semmelweis University and Westpfalz-Klinikum in Kaiserslautern, 42 first-year students began their medical studies in Budapest in September 2025, and the number of students is expected to increase to 80 per year from this year onwards. With the addition of Westpfalz-Klinikum, the number of Semmelweis University’s international campuses has grown to six.
State-of-the-art classrooms have been added to FOK and the PAK building on Kútvölgyi Street has been renovated
The teaching laboratories of the Department of Preclinical Dentistry of Semmelweis University’s Dental Education Center (FOCI) have been completely renewed and provide state-of-the-art teaching conditions. The investment of around HUF 3 billion has doubled the laboratory space to accommodate the growing number of students, and a new digital dental laboratory has been set up. The investment of nearly HUF 150 million in the András Pető Faculty building on Kútvölgyi Street covers nearly 500 square meters of academic space, including classrooms, ancillary rooms, and storage rooms.
The 33rd Semmelweis Symposium featured a more complex program than ever before
The 2025 Semmelweis Symposium, the university’s most prestigious scientific event, was held at two venues, the Városmajor Heart and Vascular Center and the Basic Medical Science Center (EOK), with a more complex program than ever before. Over 1,200 participants attended the three-day event, which featured 59 international speakers from 26 countries across the globe, from the United States and Central and Eastern Europe to Singapore, covering the full spectrum of cardiovascular medicine.
At the forefront of stem cell therapy research
The Laboratory of Stem Cell and Experimental Embryology at the Department of Anatomy, Histology and Embryology has achieved significant progress in researching the enteral nervous system and the treatment of Hirschsprung’s disease. This is the only research group in Central and Eastern Europe working on stem cell therapy for colon necrosis, and their basic research is taken forward to clinical trials by a team of doctors in the United States. The scientific community expects that in 10 years’ time, several diseases will be safely treatable with stem cell therapy.
Semmelweis University involved in testing breakthrough technology to prevent vision loss
Several researchers at Semmelweis University participated in the study led by Dr. Bence György and Dr. Botond Roska, which aims to prevent vision loss in patients suffering from a form of inherited macular degeneration. The newly developed gene-editing technique could lead to breakthroughs not only in the treatment of Stargardt disease but also in the therapy of other hereditary retinal diseases. Semmelweis University has been collaborating with world-renowned Semmelweis alumnus Dr. Botond Roska and his institute, the Institute of Molecular and Clinical Ophthalmology Basel (IOB) for more than ten years, whose mission is to cure vision loss and restore eyesight.
Semmelweis’s European Journal of Mental Health has been assigned an impact factor rating
Following a change in strategy in 2022, the journal published by the Institute of Mental Health has been assigned an impact factor rating. The editorial board of the European Journal of Mental Health set itself the goal of having the journal selected for indexing in the PubMed database, and in the longer term, the aim is to become a Q2 journal, in addition to building and expanding the research community.
Outstanding results in various sports
Semmelweis University won the 52nd edition of the Medic’s Cup in Szeged, with the participation of students from the four Hungarian medical schools, for the third time in the last four years. Approximately 250 athletes competed in 32 sports for Semmelweis University, individually and in teams, in the 2024/25 Hungarian University Championships (MEFOB), where they won a total of 13 individual championship titles.
Eszter Keresztes
Translation: Dr. Balázs Csizmadia
Photos by Bálint Barta, Boglárka Zellei – Semmelweis University